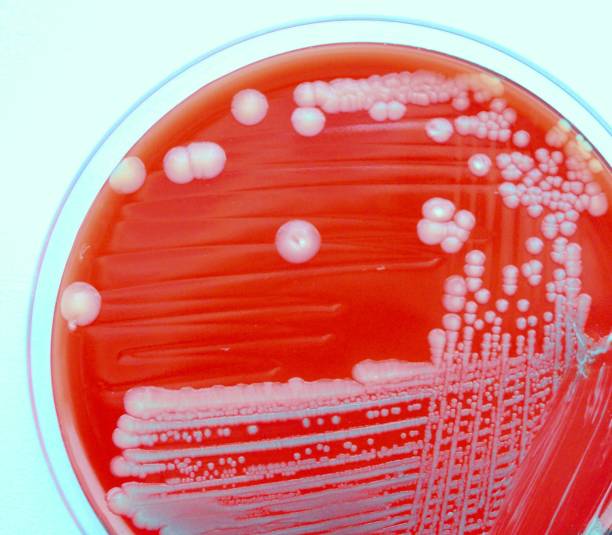

과민성 대장증후군 증상 총정리
과민성 대장증후군 증상 총정리



과민성 대장증후군은 대장 내부의 기능 이상으로 인해 복통, 변비, 설사 등의 증상이 지속되는 신경-장기질환입니다. 증상은 대개 장기능에 이상이 없는 경우에 나타나며, 일반적으로 대장 운동성의 이상과 관련이 있습니다. 이 질환은 전 세계적으로 매우 흔한 소화기 질환 중 하나입니다.



과민성 대장증후군은 대장 내부 운동성의 이상으로 인해 생기는 질환으로, 대장의 운동성은 배출물을 대장 내부에서 이동시키는데 필요합니다. 이러한 운동성의 이상으로 인해 대장의 근육이 과민반응을 보이면서 복통, 변비, 설사 등의 증상이 발생합니다. 이러한 증상은 일시적으로 나타날 수도 있고, 지속적으로 나타날 수도 있어 이번 시간에는 과민성 대장증후군 증상을 자세히 알아보도록 하겠습니다.
복통



복통은 가장 일반적인 증상 중 하나입니다. 복부의 어디든지 느껴질 수 있으며 가벼운 것부터 매우 심한 것까지 다양한 정도가 있습니다. 복통의 원인은 대부분 장 운동과 관련된 것으로 생각되며, 식사 후 발생하는 경우도 많습니다.
설사



설사는 변비와는 반대로, 대장 운동성이 과도하게 높아져서 대변이 묽고 자주 발생하는 증상입니다. 대부분의 과민성 대장증후군 환자들이 경험하는 증상 중 하나이며, 식사 후에 발생할 수도 있습니다.
변비



변비는 대장의 운동성이 감소하여 대변의 통과가 느려지는 증상으로, 대부분은 장운동을 일으키는 근육인 장폐쇄근의 이완이 감소하는 것이 원인입니다. 대부분의 과민성 대장증후군 환자들이 경험하는 증상 중 하나이며, 변비 증상이 지속되는 기간은 개인마다 다를 수 있습니다. 변비가 지속될 경우 대장 내부에 있는 플라크가 발생하여 장관의 건강에 악영향을 미칠 수 있으므로 적절한 대처가 필요합니다.
복통과 함께 발생하는 기분 변화



과민성 대장증후군 환자들은 복통과 함께 우울감, 불안, 스트레스 등의 감정적인 증상을 경험할 수 있습니다. 이는 장 내부의 불안정한 운동성과 연관이 있을 수 있으며, 때로는 다른 요인과도 관련이 있을 수 있습니다.
배탈감

과민성 대장증후군 환자들은 종종 배탈감을 느끼기도 합니다. 이는 식사 후나 배가 공복할 때, 혹은 스트레스와 같은 감정적인 변화가 있을 때 발생할 수 있습니다. 배탈감이 지속될 경우, 식사량이 감소하거나 영양분의 흡수가 제한될 수 있으므로 조기 진단과 치료가 필요합니다.
가스



과민성 대장증후군 환자들은 가스를 많이 발생시키는 경향이 있습니다. 이는 대장 내부의 운동성이 불안정하여 음식물이 빠르게 소화되지 않고 대장에서 장시간 머무르는 것과 관련이 있을 수 있습니다. 이러한 가스 발생으로 인해 복통이나 복부팽만감 등의 증상이 발생할 수 있으므로 조기 진단과 적절한 치료가 필요합니다.
체중 감소



일부 과민성 대장증후군 환자들은 체중 감소 증상을 경험할 수 있습니다. 이는 배탈감이나 변비 증상으로 인해 식사량이 감소하는 경우와, 대장 내부의 염증이나 질병으로 인해 영양분이 흡수되지 않는 경우가 있습니다. 체중 감소는 이러한 증상들과 연관되어 있으므로, 적극적인 치료가 필요합니다.
뇌동맥류 증상 자세히 알아보기
뇌동맥류 증상 자세히 알아보기 뇌동맥류는 뇌의 혈관이 벽의 약한 부분이나 손상으로 인해 팽창하거나 부풀어 오른 상태를 말합니다. 뇌동맥류는 일반적으로 증상이 없으며, 우연히 발견되기
wjdqhakstp.goodtory.kr
뇌출혈 전조 증상 자세히 알아보기
뇌출혈 전조 증상 자세히 알아보기 뇌출혈은 뇌안에 있는 혈관에서 출혈이 발생하여 뇌조직이 손상을 입는 질환이며, 중증의 뇌혈관질환 중 하나입니다. 일반적으로 고혈압, 동맥류, 혈관 기형,
wjdqhakstp.goodtory.kr
모야모야병 증상 제대로 알아보기
모야모야병 증상 제대로 알아보기 모야모야병은 중추신경계 질환 중 하나로, 이상한 소리와 자세, 신체적인 증상 등을 일으키는 질환입니다. 이 병은 실제로는 정신의학적인 질환으로 분류되며
wjdqhakstp.goodtory.kr